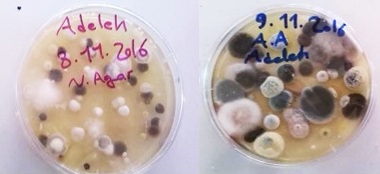

Güncel Haber
Toz ve Covid-19, Prof. Dr. Cemal Saydam yazdı...
17 Kasım 2020 | Bekir Metin | Güncel Haber
Nereden bilebilirdik böyle günler de göreceğimizi. Bir musibet virüs tüm hayatımızı değiştirdi. Hiç alışmadığımız her şey hayatımıza girdi. Alıştık mı? Yok, hala alışmaya çalışıyoruz. Kulağımın üzerinde gözlük sapı dururdu son teknoloji birde kulaklık sokuşturmuştu kulağıma ama şimdi birde maskenin lastiği. Zamanla da acı veren bir uzantı ama onsuz da olmuyor. Aldığımız havayı filtre etmek veya virüs kapmışsak oku etrafa yaymamak için hakikaten gerekli bir şey. Virüs taşıyan kişi ile bizim aramızdaki ilişkiyi hava sağlıyor. Virüs havadan bulaşıyor ama oradaki yaşam süreci de kısıtlı. Virüs zaten kendi başına yaşayan bir şey de değilmiş. Yaşaması için bakteri mantar gibi yaşam fonksiyonları olan bir biyolojik yapıya tutunmak zorundaymış.
Allah’ın havasını geçmişte ısınma için yaktığımız kömürün dumanı ile kirletirdik şimdi de virüsle kirletir olduk. Havamıza bile dokundu bu virüs illeti.
Bu virüsün temas veya damlacıklar aracılığı ile taşıyıcı kişiler aracılığı ile yayıldığı bilinen bir gerçektir. Dolayısı ile her iki durumda da mesafe ne olursa olsun virüs hasta kişiden bir diğerine giderken hava ile temas etmek durumundadır. Bu da bizi havanın içerdiği maddelerin daha detaylı incelenmesine doğru yönlendirmektedir.

Bilinen hava belirli oranlarda azot oksijen ve diğer gazları içermektedir. Modern yaşam bunlara kirlilik olarak adlandırılan karbon dioksit metan sülfür ve azot gazlarını da ilave etmektedir. Son günlerde yurdun iç bölgelerinde kuraklık ve ani hava değişimine bağlı olarak atmosfere çıkan tozlar da bu yoğunlukta bize yabancı olduğu için acaba virüs bu havada yayılabilir mi endişesini gündeme getirmiştir.
Toz taşınımı aslında yabancısı olduğumuz bir olgu değildir. Özellikle bahar ve sonbaharda yurdumuza Sahra çöllerinden önemli miktarda toz yurdumuza gelmekte ve yağışla yere indiğinde de bu yağmurlar toplum tarafından bereket rahmet olarak adlandırılmaktadır.
İşin püf noktası da burada yatmakta ve bu tozlar belirli koşullarda havadaki bakteri mantar sayılarını önemli miktarda arttırmaktadır. Türk bilim insanları yaptıkları çalışmalarda özellikle Sahra çölünden gelen hava akımları sürecinde atmosferdeki mikroorganizmaların olağanüstü bir şekilde arttığını göstermişlerdir. Hava akımlarının kuzeyden geldiği dönemlerde ise havadaki mikroorganizma sayıları sıfıra kadar inmektedir.

Kuzeyli havadan alınan örnek Sahra çölünden gelen havada yapılan örnekleme
Sahra çölünden gelen hava akımlarının bulut ile karışması sonucunda ise tozun adı da çamur olarak değişmekte ancak bulut içerisinde oluşan bir dizi reaksiyon sonucunda atmosferik koşullar havadaki mikroorganizmaların bırakın yaşamasını çoğalmasına dahi olanak verecek koşulları oluşturmaktadırlar. Bulut içi reaksiyonların önemi her nedense bilim dünyası tarafından yeterince anlaşılamamıştır ancak toz bulut ve güneş enerjisi birleşince ortaya metan ve karbon monoksit gibi sera gazları da çıkmakta ve bunlar örneğin Avrupa Birliği dolayısı ile Sahra tozu taşınımı sürecinde herhangi bir taşıyıcının havaya çıkartacağı virüs yaşamasına olanak verecek bir ortam ile karşılamakta ve varsayılandan çok ama çok daha uzağa hatta onlarca belki de yüzlerce kilometrelerce uzaklara taşınabilmektedir.
Sahra çölünün Amerika kıtasına doğru Haziran ayının ikinci yarısında çıkardığı çok yoğun tozun önce güney Amerika’ya daha sonra Pan-Amerikan ülkelerine ve daha sonra da ABD güney eyaletlerine ulaşmasını takip eden 6/7 günde her ülkedeki yeni vaka sayıları olağanüstü bir şekilde artmıştır. Örneğin ABD genelinde yaşanan (BLM) toplumsal olaylar sürecinde yeni vaka sayılarında hiç oynama olmamışken Sahra tozunun güney eyaletlere ulaşmasını takip eden 6/7 günde yeni vaka sayıları pandemi sürecinde hiç görülmemiş olağan üstü sayılara ulaşmıştır.
Tozun Avrupa kıtasındaki yeni vaka sayıları üzerindeki etkilerini de görmek kesinlikle mümkündür. Zaten bu ilişkinin olasılığı 16-22 2020 Mart 2020 tarihlerinde İberya Yarımadasını etkileyen tozlu ve bulutlu havanın etkisini yitirmesinde sonraki 6/7 günde İspanya ve Portekiz’de izlenen yeni vaka sayılarındaki ani artış sonrası ilenmeye başlanmıştır. Bu etkinin geçerliliği sadece Sahra toz taşınımı ile de sınırlı olmayıp küresel boyutta her çöl tozunun etkilediği bölgelerdeki yeni vaka sayılarındaki artışları izlemek ile perçinlenmiştir.
Örneğin Yeni Zelanda’da izlenen ani artışın Avustralya çölünden gelen tozlu hava akımlarına bağlı olduğunu gösterebiliyoruz.
Gobi Çölü ise Çin, Kore ve Japonya’daki vaka sayılarındaki artışı net bir şekilde açıklayabilmektedir.
Tozsuz havalarda ise yeni vaka sayılarında yine 6/7 gün sonra ani düşüşler izlenmiştir. Bu da atmosferik taşınımının ne kadar etkili olduğunun bir başka destekleyici bulgusu olmuştur.
Bu yaklaşımın en güzel tarafı ise elimizdeki teknolojik imkânlar ile topluma toz ve bulutlu havanın ne zaman bizi etkileyeceğini en az üç gün önceden söyleyebilir en azından bu dönemlerde dış mekânlarda olmamalarını veya mecburlarsa sosyal mesafeyi en az 3-5 kat daha arttırmalarını sağlayabilir ve virüsün yayılımını engelleyebiliriz.
İlk bakışta hadi canım sende dedirtecek bu yaklaşımın yakın bir gelecekte tüm dünya ülkeleri tarafından benimsenmesi halinde sınır tanımayan bu virüs ile mücadele edebiliriz. Aksi halde ülke bazında virüse karşı zafer kazanmanın hiçbir anlamı kalmayacaktır çünkü virüs atmosferik koşullar uygun ise bize göre binlerce kilometre bile taşınabilmektedir.

Amerika kıtasına ulaşan tozlu havanın 19 Haziran’daki durumu. Bu sistemin Amerika kıtasında nereye ne zaman ulaşacağını önceden tahmin edebileceğimiz için o bölgelere en az 3 gün önceden haber vermek ve toplumun dış mekânlarda olmamasını sağlamak ve dolayısı ile vaka sayılarındaki artışı kontrol etmek mümkün olabilirdi.
Toz bulut ve Covid-19 ilişkisinin en son örneği olarak 6/7 Kasım 2020 günlerinde İberya’yı etkileyen hava akımlarına dikkat çekmiş ve bu olayın toplum üzerindeki ekişini 12/13 Kasım 2020 günlerinde göreceğimizi söylemiştim. 6/7 günlük gecikme virüsün inkübasyon süresi olarak aradan geçmesi gereken gün olarak algılanmalıdır.
Olay 6/7 Kasım’da meydana geldi ve biz bunu uydu verilerinden de takip ettik.

6/7 Kasım günlerinde İber yarımadasını etkileyen hava kütlesinin 6 Kasım 2020 gününe ait uydu görüntüsü.
İspanya ve Portekiz’de benim teorime göre yeni vaka sayılarında artış beklediğim 12/13 Kasım 2020 günlerine ait veriler de aşağıda;
Ne acıdır ki deneklerim insan ve yeni vaka sayıları benim yaklaşımımı bir kez daha kanıtlamış oldu.
Vaka sayılarının artması demek bundan sonraki toz bulut etkileşimi ile virüsün daha da çok yayılacağı anlamına gelmektedir.

Halbuki toz bulut durumunu 3 gün öncesinden kesine yakın bir şekilde tahmin edebiliyoruz.
Örneğin küresel anlamda baktığımızda 18 Kasım 2020 günü Çin’in Wuhan Eyaletini etkileyecek yoğun toz taşınmasını görmek mümkün.
Aynı tahmin yöntemi ile 18 Kasım 2020 günü havanın bulutlu ve yağışlı olacağını da söyleyebiliriz.
Yani toz ve bulut olan bölgelerde virüs yayılabilmek için çok daha uygun ortam bulabilecek.
Eğer yerde de taşıyıcı var ise bunlardan etrafa yayılacak virüsler bu hava kütlesi içerisinde çok daha etkili olabilecek.
Demek ki 18/19 Kasım günleri için o bölgelerde sokağa çıkmanın kısıtlı olması lazım.
Bunu da mutlaka yasaklar ile yapacağımıza toplumu bilinçlendirerek yapmak ve virüsün böyle yayılımını engellemek durumundayız.
Yazar Prof. Dr. Cemal Saydam, Ankara, 17.11.2020
Allah’ın havasını geçmişte ısınma için yaktığımız kömürün dumanı ile kirletirdik şimdi de virüsle kirletir olduk. Havamıza bile dokundu bu virüs illeti.
Bu virüsün temas veya damlacıklar aracılığı ile taşıyıcı kişiler aracılığı ile yayıldığı bilinen bir gerçektir. Dolayısı ile her iki durumda da mesafe ne olursa olsun virüs hasta kişiden bir diğerine giderken hava ile temas etmek durumundadır. Bu da bizi havanın içerdiği maddelerin daha detaylı incelenmesine doğru yönlendirmektedir.

Bilinen hava belirli oranlarda azot oksijen ve diğer gazları içermektedir. Modern yaşam bunlara kirlilik olarak adlandırılan karbon dioksit metan sülfür ve azot gazlarını da ilave etmektedir. Son günlerde yurdun iç bölgelerinde kuraklık ve ani hava değişimine bağlı olarak atmosfere çıkan tozlar da bu yoğunlukta bize yabancı olduğu için acaba virüs bu havada yayılabilir mi endişesini gündeme getirmiştir.
Toz taşınımı aslında yabancısı olduğumuz bir olgu değildir. Özellikle bahar ve sonbaharda yurdumuza Sahra çöllerinden önemli miktarda toz yurdumuza gelmekte ve yağışla yere indiğinde de bu yağmurlar toplum tarafından bereket rahmet olarak adlandırılmaktadır.
İşin püf noktası da burada yatmakta ve bu tozlar belirli koşullarda havadaki bakteri mantar sayılarını önemli miktarda arttırmaktadır. Türk bilim insanları yaptıkları çalışmalarda özellikle Sahra çölünden gelen hava akımları sürecinde atmosferdeki mikroorganizmaların olağanüstü bir şekilde arttığını göstermişlerdir. Hava akımlarının kuzeyden geldiği dönemlerde ise havadaki mikroorganizma sayıları sıfıra kadar inmektedir.
Kuzeyli havadan alınan örnek Sahra çölünden gelen havada yapılan örnekleme
Sahra çölünden gelen hava akımlarının bulut ile karışması sonucunda ise tozun adı da çamur olarak değişmekte ancak bulut içerisinde oluşan bir dizi reaksiyon sonucunda atmosferik koşullar havadaki mikroorganizmaların bırakın yaşamasını çoğalmasına dahi olanak verecek koşulları oluşturmaktadırlar. Bulut içi reaksiyonların önemi her nedense bilim dünyası tarafından yeterince anlaşılamamıştır ancak toz bulut ve güneş enerjisi birleşince ortaya metan ve karbon monoksit gibi sera gazları da çıkmakta ve bunlar örneğin Avrupa Birliği dolayısı ile Sahra tozu taşınımı sürecinde herhangi bir taşıyıcının havaya çıkartacağı virüs yaşamasına olanak verecek bir ortam ile karşılamakta ve varsayılandan çok ama çok daha uzağa hatta onlarca belki de yüzlerce kilometrelerce uzaklara taşınabilmektedir.
Sahra çölünün Amerika kıtasına doğru Haziran ayının ikinci yarısında çıkardığı çok yoğun tozun önce güney Amerika’ya daha sonra Pan-Amerikan ülkelerine ve daha sonra da ABD güney eyaletlerine ulaşmasını takip eden 6/7 günde her ülkedeki yeni vaka sayıları olağanüstü bir şekilde artmıştır. Örneğin ABD genelinde yaşanan (BLM) toplumsal olaylar sürecinde yeni vaka sayılarında hiç oynama olmamışken Sahra tozunun güney eyaletlere ulaşmasını takip eden 6/7 günde yeni vaka sayıları pandemi sürecinde hiç görülmemiş olağan üstü sayılara ulaşmıştır.
Tozun Avrupa kıtasındaki yeni vaka sayıları üzerindeki etkilerini de görmek kesinlikle mümkündür. Zaten bu ilişkinin olasılığı 16-22 2020 Mart 2020 tarihlerinde İberya Yarımadasını etkileyen tozlu ve bulutlu havanın etkisini yitirmesinde sonraki 6/7 günde İspanya ve Portekiz’de izlenen yeni vaka sayılarındaki ani artış sonrası ilenmeye başlanmıştır. Bu etkinin geçerliliği sadece Sahra toz taşınımı ile de sınırlı olmayıp küresel boyutta her çöl tozunun etkilediği bölgelerdeki yeni vaka sayılarındaki artışları izlemek ile perçinlenmiştir.
Örneğin Yeni Zelanda’da izlenen ani artışın Avustralya çölünden gelen tozlu hava akımlarına bağlı olduğunu gösterebiliyoruz.
Gobi Çölü ise Çin, Kore ve Japonya’daki vaka sayılarındaki artışı net bir şekilde açıklayabilmektedir.
Tozsuz havalarda ise yeni vaka sayılarında yine 6/7 gün sonra ani düşüşler izlenmiştir. Bu da atmosferik taşınımının ne kadar etkili olduğunun bir başka destekleyici bulgusu olmuştur.
Bu yaklaşımın en güzel tarafı ise elimizdeki teknolojik imkânlar ile topluma toz ve bulutlu havanın ne zaman bizi etkileyeceğini en az üç gün önceden söyleyebilir en azından bu dönemlerde dış mekânlarda olmamalarını veya mecburlarsa sosyal mesafeyi en az 3-5 kat daha arttırmalarını sağlayabilir ve virüsün yayılımını engelleyebiliriz.
İlk bakışta hadi canım sende dedirtecek bu yaklaşımın yakın bir gelecekte tüm dünya ülkeleri tarafından benimsenmesi halinde sınır tanımayan bu virüs ile mücadele edebiliriz. Aksi halde ülke bazında virüse karşı zafer kazanmanın hiçbir anlamı kalmayacaktır çünkü virüs atmosferik koşullar uygun ise bize göre binlerce kilometre bile taşınabilmektedir.

Amerika kıtasına ulaşan tozlu havanın 19 Haziran’daki durumu. Bu sistemin Amerika kıtasında nereye ne zaman ulaşacağını önceden tahmin edebileceğimiz için o bölgelere en az 3 gün önceden haber vermek ve toplumun dış mekânlarda olmamasını sağlamak ve dolayısı ile vaka sayılarındaki artışı kontrol etmek mümkün olabilirdi.
Toz bulut ve Covid-19 ilişkisinin en son örneği olarak 6/7 Kasım 2020 günlerinde İberya’yı etkileyen hava akımlarına dikkat çekmiş ve bu olayın toplum üzerindeki ekişini 12/13 Kasım 2020 günlerinde göreceğimizi söylemiştim. 6/7 günlük gecikme virüsün inkübasyon süresi olarak aradan geçmesi gereken gün olarak algılanmalıdır.
Olay 6/7 Kasım’da meydana geldi ve biz bunu uydu verilerinden de takip ettik.

6/7 Kasım günlerinde İber yarımadasını etkileyen hava kütlesinin 6 Kasım 2020 gününe ait uydu görüntüsü.
İspanya ve Portekiz’de benim teorime göre yeni vaka sayılarında artış beklediğim 12/13 Kasım 2020 günlerine ait veriler de aşağıda;
Ne acıdır ki deneklerim insan ve yeni vaka sayıları benim yaklaşımımı bir kez daha kanıtlamış oldu.
Vaka sayılarının artması demek bundan sonraki toz bulut etkileşimi ile virüsün daha da çok yayılacağı anlamına gelmektedir.

Halbuki toz bulut durumunu 3 gün öncesinden kesine yakın bir şekilde tahmin edebiliyoruz.
Örneğin küresel anlamda baktığımızda 18 Kasım 2020 günü Çin’in Wuhan Eyaletini etkileyecek yoğun toz taşınmasını görmek mümkün.
Aynı tahmin yöntemi ile 18 Kasım 2020 günü havanın bulutlu ve yağışlı olacağını da söyleyebiliriz.
Yani toz ve bulut olan bölgelerde virüs yayılabilmek için çok daha uygun ortam bulabilecek.
Eğer yerde de taşıyıcı var ise bunlardan etrafa yayılacak virüsler bu hava kütlesi içerisinde çok daha etkili olabilecek.
Demek ki 18/19 Kasım günleri için o bölgelerde sokağa çıkmanın kısıtlı olması lazım.
Bunu da mutlaka yasaklar ile yapacağımıza toplumu bilinçlendirerek yapmak ve virüsün böyle yayılımını engellemek durumundayız.
Yazar Prof. Dr. Cemal Saydam, Ankara, 17.11.2020
DSÖ (WHO)
GTÖ (FAO)
UNEP
DHSÖ (WOAH)